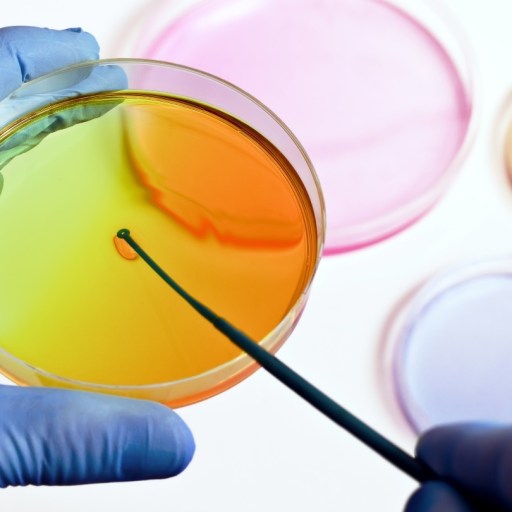

Search
Robby Berman
Contributing Writer
I’m a writer, musician, and father living in central New York with my wife, two daughters, one dog, two cats, and countless questions. I’m especially interested in animal rights, creativity, politics, the nature of things and time, and in making a worthwhile contribution. You can follow me @everyrobby.
Read Less

The sudden prevalence of an artery in the forearm is evidence that we're still very much a work in progress.

While it's always been a boon to Popeye's "muskles," it looks like spinach may also have a role to play in clean future batteries.

Researchers from the University of Toronto published a new map of cancer cells' genetic defenses against treatment.

A new study finds that starlet sea anemones have the unique ability to grow more tentacles when they've got more to eat.

Construction is nearly complete for a camera that will take 3,200-megapixel panoramas of the southern night sky.